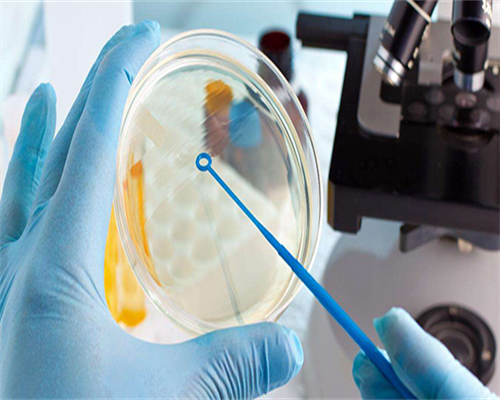
试管代孕中心,染色体异常的孩子能生吗!染色体异常能生出健康宝宝吗!

试管代孕中心,染色体异常的孩子能生吗!染色体异常能生出健康宝宝吗!
中国的政策提倡优生优育,同时,让孩子健康成长也是每个父母的心愿。有些家庭在怀孕后的检查中发现宝宝存在染色体异常,但他们对染色体异常并不了解,也不知道染色体异常的孩子会怎么样,下面我们就来了解一下染色体异常的相关知识。
染色体异常的孩子能出生吗?染色体异常是指染色体的形状或数目与正常人不同。染色体异常会导致胎儿在妊娠早期容易流产,或者胎儿在发育过程中停止发育。在怀孕中期,染色体异常的胎儿很可能会出现畸形,这在超声波检查中可以清楚地观察到。染色体异常的影响并不会在孩子出生后就结束,因为与正常的同龄人相比,他们往往会出现智力低下和发育迟缓。总之,不建议生育染色体异常的孩子。
为什么会出现染色体异常?1、产妇年龄本身过大,超过35岁的高龄产妇的卵子发生老化变化,对染色体的后期分裂有一定的影响,从而导致染色体异常。
2、受环境影响,工业的发展对我们现在的生活环境造成了污染,长期处于辐射环境或者接触一些有害的化学物质都会使染色体发生变异,从而导致染色体异常。
3、染色体异常往往与家族遗传有关,如果父母双方都有染色体异常的家族,那么婴儿出现染色体异常的概率也会大大增加。
目前,医学界对染色体异常还没有有效的解决办法,所以我们需要在孕期或已经怀上宝宝的家庭定期做检查,及时了解胎儿的生长发育情况,以便能够及时处理染色体异常。
在条件允许的情况下,一些家庭可以选择试管婴儿技术来降低婴儿染色体异常的风险。目前,第三代试管婴儿技术会在胚胎移植前进行基因诊断和筛查,这一步骤会排除携带染色体异常或其他遗传疾病的胚胎,将剩下的优质胚胎移植到女性体内孕育,这在一定程度上可以降低胎儿患病的可能性。
p捐卵生儿子